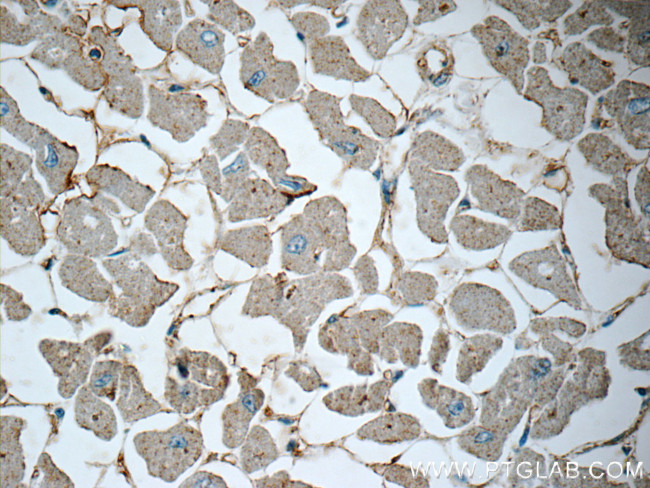
Renin receptor/ATP6AP2 Antibody in Immunohistochemistry (Paraffin) (IHC (P))

Search
Proteintech
Renin receptor/ATP6AP2 Polyclonal Antibody
{{$productOrderCtrl.translations['antibody.pdp.commerceCard.promotion.promotions']}}
{{$productOrderCtrl.translations['antibody.pdp.commerceCard.promotion.viewpromo']}}
{{$productOrderCtrl.translations['antibody.pdp.commerceCard.promotion.promocode']}}: {{promo.promoCode}} {{promo.promoTitle}} {{promo.promoDescription}}. {{$productOrderCtrl.translations['antibody.pdp.commerceCard.promotion.learnmore']}}
产品信息
10926-1-AP
种属反应
已发表种属
宿主/亚型
分类
类型
抗原
偶联物
形式
浓度
规格
纯化类型
保存液
内含物
保存条件
运输条件
产品详细信息
Immunogen sequence: MYSLYGGNA VVELVTVKSF DTSLIRKTRT ILEAKQANPA SPYNLAYKYN FEYSVVFNMV LWIMIALALA VIITSYNIWN MDPGYDSIIY RMTNQKIRMD (1-99 aa encoded by BC010395 )
靶标信息
This gene encodes a protein that is associated with adenosine triphosphatases (ATPases). Proton-translocating ATPases have fundamental roles in energy conservation, secondary active transport, acidification of intracellular compartments, and cellular pH homeostasis. There are three classes of ATPases- F, P, and V. The vacuolar (V-type) ATPases have a transmembrane proton-conducting sector and an extramembrane catalytic sector. The encoded protein has been found associated with the transmembrane sector of the V-type ATPases.
仅用于科研。不用于诊断过程。未经明确授权不得转售。
生物信息学
蛋白别名: (pro)renin receptor; ATP6M8-9; ATPase H(+)-transporting lysosomal accessory protein 2; ATPase H(+)-transporting lysosomal-interacting protein 2; ATPase, H(+)-transporting, lysosomal-interacting protein 2; ATPase, H+ transporting, lysosomal (vacuolar proton pump) membrane sector associated protein M8-9; ATPase, H+ transporting, lysosomal accessory protein 2; ATPase, H+ transporting, lysosomal interacting protein 1; ATPase, H+ transporting, lysosomal interacting protein 2; Embryonic liver differentiation factor 10; ER-localized type I transmembrane adapter; ER-localized type I transmembrane adaptor; member protein; MGC99577; N14F; prorenin receptor; Renin receptor; Renin/prorenin receptor; unnamed protein product; V-ATPase M8.9 subunit; Vacuolar ATP synthase membrane sector-associated protein M8-9; vacuolar proton ATP synthase membrane sector associated protein M8-9
基因别名: (P)RR; 5730403E06Rik; APT6M8-9; ATP6AP2; ATP6IP2; ATP6M8-9; CAPER; CDG2R; ELDF10; HT028; M8-9; MRXE; MRXSH; MSTP009; PRR; PSEC0072; RENR; XMRE; XPDS
UniProt ID: (Human) O75787, (Rat) Q6AXS4, (Mouse) Q9CYN9
Entrez Gene ID: (Human) 10159, (Rat) 302526, (Mouse) 70495